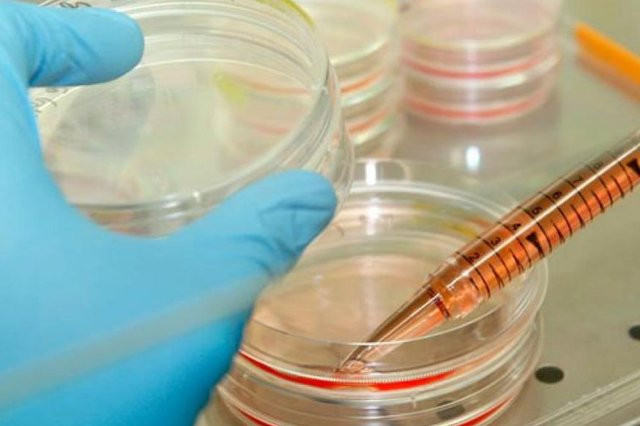

У подхвативших кишечную инфекцию благовещенских школьников обнаружен норовирус
Ученики гимназии № 25 Благовещенска, госпитализированные с кишечной инфекцией, заразились норовирусом. Таковы результаты расследования, проведенного амурским управлением Роспотребнадзора по факту массового заболевания школьников. Сейчас в больнице находятся четверо детей. Родители учеников начальных классов гимназии, обратившиеся в редакцию АП, сообщили, что заболевших гораздо больше.
«По состоянию на 20 часов 16 ноября новых детей с клиническими проявлениями инфекционных заболеваний не зарегистрировано. В стационаре находится четыре ребенка. Состояние детей удовлетворительное. При обследовании заболевших детей выделен норовирус. Все контактные дети находятся под медицинским наблюдением», — говорится в официальном сообщении управления Роспотребнадзора по Амурской области.
Уроки в школе сейчас не проводятся, потому что с сегодняшнего дня, 17 ноября, начались плановые каникулы.
Чтобы установить источник инфекции, специалисты Роспотребнадзора и Центра гигиены и эпидемиологии провели проверку деятельности гимназии, работы пищеблока, поставщиков полуфабрикатов и сырья — это продукты МКП «Комбинат школьного питания» и бутилированной воды ООО «Еврокар», которую заказывали для питья в классы, где заболели дети.
Во время эпидемиологического расследования специалисты провели более 180 вирусологических исследований: продуктов питания (компот, макароны отварные, сосиски, рис, пирожок, плов и др.), суточных проб пищевых продуктов, сырьевые компоненты (яйцо, колбаса, куриное филе, огурец), смывов с объектов внешней среды, воды питьевой из централизованного водоснабжения, воды бутилированной, материала от персонала пищеблока и комбината МКП «Комбинат школьного питания» на возбудителей норо-, астро-, энтеро, ротавирусов, сальмонеллеза, кампилобактера, дизентерии и стафилококковой инфекции. По результатам исследований возбудителей инфекционных заболеваний не обнаружено, сообщает Роспотребнадзор.
Все готовые продукты, отмечает ведомство, имеют качественную термическую обработку. Обработка посуды в пищеблоке и комбинате школьного питания также соответствует требованиям санитарных правил.
Связи между организацией питания в гимназии с заболеваемостью младших школьников не установлено. «Групповая заболеваемость обусловлена норовирусной инфекцией с контактно-бытовым путем передачи», — сообщает амурское управление Роспотребнадзора.
Справка
Норовирусная инфекция относится к группе острых кишечных инфекций. Источником инфекции является больной человек или бессимптомный носитель вируса. Инкубационный период составляет от 12 до 48 часов. Продолжительность заболевания — 2-5 дней. Вирус передается контактно-бытовым, пищевым или водным путем.




